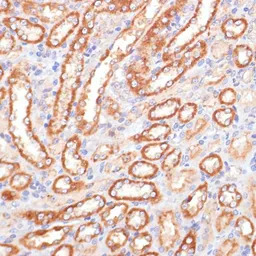
Cytochrome b5 antibody

相关产品推荐更多 >
万千商家帮你免费找货
0 人在求购买到急需产品
- 详细信息
- 文献和实验
- 技术资料
- 免疫原:
Recombinant fusion protein containing a sequence corresponding to amino acids 1-100 of human CYB5A (NP_683725.1).
- 亚型:
IgG
- 形态:
Liquid
- 保存条件:
Store as concentrated solution. Centrifuge briefly prior to opening vial. For short-term storage (1-2 weeks), store at 4ºC. For long-term storage, aliquot and store at -20ºC or below. Avoid multiple freeze-thaw cycles.
- 克隆性:
Polyclonal
- 标记物:
Unconjugated
- 适应物种:
Human, Mouse, Rat
- 保质期:
12 months from the shipping date of the product.
- 抗原来源:
Human
- 目录编号:
GTX53959
- 级别:
Primary Antibodies
- 库存:
Available
- 供应商:
GeneTex
- 宿主:
Rabbit
- 应用范围:
WB, ICC/IF, IHC-P
- 浓度:
Batch dependent (Please refer to the vial label for the specific concentration.)
- 靶点:
Cytochrome b5
- 抗体英文名:
Cytochrome b5 antibody
- 抗体名:
Cytochrome b5 抗体
- 规格:
100 μl

WB analysis of various sample lysates using GTX53959 Cytochrome b5 antibody.
Dilution : 1:1000
Loading : 25μg per lane

IHC-P analysis of mouse heart tissue using GTX53959 Cytochrome b5 antibody.
Dilution : 1:100

ICC/IF analysis of C6 cells using GTX53959 Cytochrome b5 antibody.
Blue : DAPI
Dilution : 1:100
IHC-P analysis of rat kidney tissue using GTX53959 Cytochrome b5 antibody.
Dilution : 1:100
风险提示:丁香通仅作为第三方平台,为商家信息发布提供平台空间。用户咨询产品时请注意保护个人信息及财产安全,合理判断,谨慎选购商品,商家和用户对交易行为负责。对于医疗器械类产品,请先查证核实企业经营资质和医疗器械产品注册证情况。
 文献和实验
文献和实验细胞色素b5 存于高等动物内质网膜的一种细胞色素。可从兔肝微粒体中提纯。因为与膜结合,用蛋白酶或表面活性剂处理可以使其溶解。还原型和氧化型的最大吸收光谱分别为 555、 526、 423和 414毫微米,分子量为 12, 500,氧化还原电位+ 0.02V。可由同样内质网膜内的还原酶通过 NADH进行还原。还原型 b5与被称为氰感受因子的酶一起,参与由氧将饱和酰基辅酶 A转变成不饱和酰基辅酶 A的脂肪酸不饱和化反应。
In Vitro Identification of Cytochrome P450 Enzymes Responsible for Drug Metabolism
Metabolism catalyzed by the cytochrome P450 enzymes (CYPs) represents the most important pathway for drug metabolism and elimination in humans. Identification of the CYPs responsible for metabolism of existing and novel drugs is critical
secondary antibody review -- data from 99 publications
cytometry used as a control to detect cell responses targeted antigen 7 Alexa Fluor 488 7 Cy3 8 goat IgG Alexa Fluor 488 1:2000 detect antibody binding in human embryonic kidney 293T cells Invitrogen 9 donkey
 技术资料
技术资料暂无技术资料 索取技术资料





![VE-Cadherin antibody [GT1369]](https://img1.dxycdn.com/2022/0329/030/4096298082347020453-14.jpg!wh200)
![RAS antibody [AT2G9]](https://img1.dxycdn.com/2022/0328/246/4322473721370800453-14.jpg!wh200)


![Lamin A + C antibody [GT9712]](https://img1.dxycdn.com/2022/0329/124/3570269911965020453-14.jpg!wh200)

